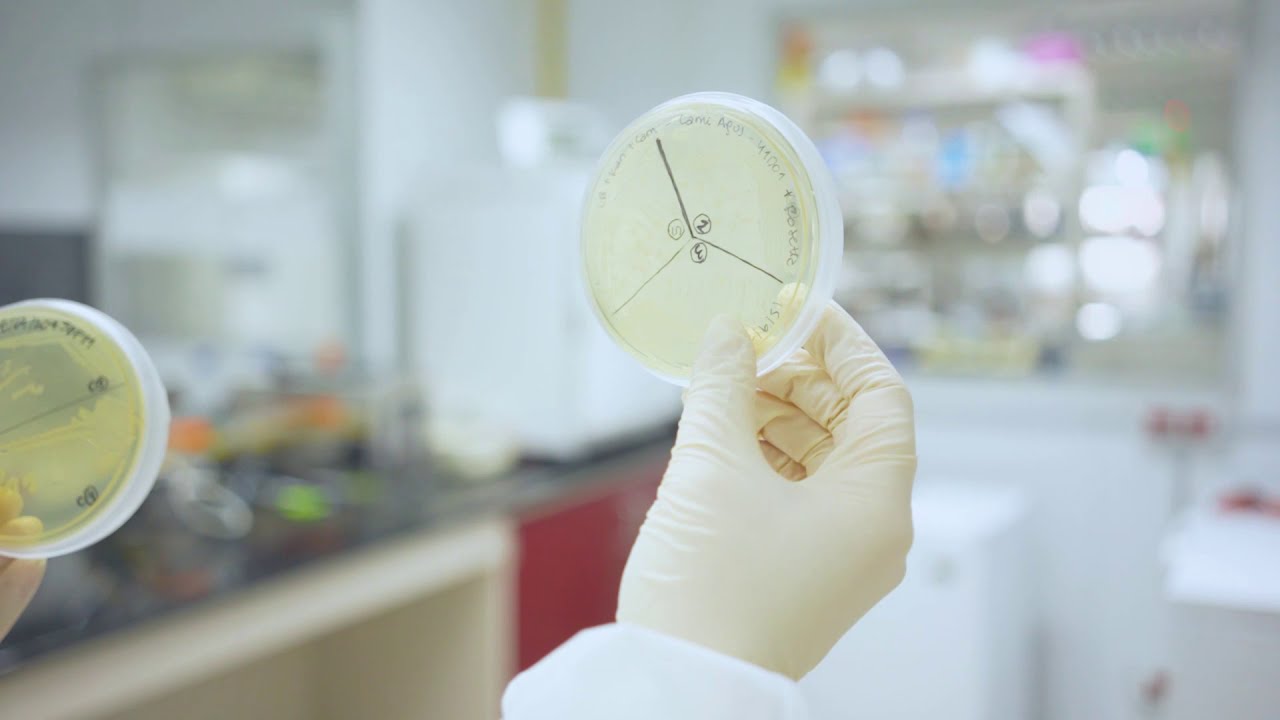
Las tendencias en biotecnología que los emprendedores deben conocer

1. Introducción a las tendencias actuales en biotecnología
La biotecnología es un campo en constante evolución que combina la biología con la tecnología para desarrollar productos y procesos que pueden mejorar la salud, la agricultura y el medio ambiente. En la actualidad, hay varias tendencias clave que están dando forma a esta industria dinámica.
Tendencias en la investigación biotecnológica
La investigación en biotecnología se ha visto impulsada por innovaciones en la edición genética, especialmente con tecnologías como CRISPR-Cas9, que permiten realizar modificaciones precisas en el ADN de organismos.
- Edición genética: La posibilidad de alterar genes ha abierto nuevas oportunidades para el tratamiento de enfermedades genéticas y el desarrollo de cultivos más resistentes.
- Biología sintética: Esta tendencia permite la creación de organismos personalizados que pueden producir compuestos de interés, como biofármacos y biocombustibles.
Avances en terapia génica y celular
La terapia génica ha avanzado notablemente en los últimos años, proporcionando nuevas esperanzas para pacientes con enfermedades raras y complejas. Las innovaciones incluyen:
- Vectores virales: Se utilizan para entregar material genético modificado directamente a las células del paciente.
- Células CAR-T: Terapias que modifican las células inmunitarias del paciente para atacar células cancerosas específicas.
Biotecnología en la agricultura
La biotecnología también está revolucionando la agricultura a través del desarrollo de cultivos genéticamente modificados (GMOs) que son más resistentes a plagas y enfermedades.
- Algodón Bt: Un cultivo modificado que se protege contra insectos dañinos.
- Marihuana medicinal: Un área de creciente interés donde se usan técnicas biotecnológicas para potenciar sus propiedades curativas.
Bioinformática y análisis de datos
La bioinformática se ha convertido en una herramienta crucial en la biotecnología, permitiendo la gestión y análisis de grandes volúmenes de datos biológicos. Esta tendencia incluye:
- Big Data: Análisis de datos masivos para identificar patrones y correlaciones en la investigación genética.
- Inteligencia artificial: Uso de algoritmos avanzados para acelerar el descubrimiento de nuevos fármacos y tratamientos.
Aplicaciones en farmacología
La biotecnología está transformando la **farmacología** a través de la creación de fármacos biológicos. Estos son producidos utilizando organismos vivos y ofrecen tratamientos más específicos y efectivos.
- Anticuerpos monoclonales: Utilizados en terapia contra diversas enfermedades, incluyendo cáncer.
- Vacunas recombinantes: Desarrollo rápido de vacunas contra enfermedades emergentes y reemergentes.
Sostenibilidad y biotecnología ambiental
Las tendencias actuales también están impulsadas por la necesidad de prácticas más sostenibles en la producción industrial. La biotecnología ambiental se centra en:
- Bioremediación: Uso de microorganismos para limpiar contaminantes en el medio ambiente.
- Producción de biocombustibles: Creación de fuentes de energía renovables a partir de biomasa.
Colaboraciones interdisciplinarias
La biotecnología también ha visto un aumento en las colaboraciones interdisciplinarias. Investigadores de diferentes campos trabajan juntos para abordar desafíos complejos. Ejemplos incluyen:
- Colaboraciones entre investigadores y clínicos: Para acelerar el desarrollo de nuevas terapias.
- Alianzas entre industrias: Compañías farmacéuticas colaboran con empresas tecnológicas para innovación en el desarrollo de productos.
Regulación y ética en biotecnología
A medida que la biotecnología avanza, también aumenta la preocupación por las cuestiones regulatorias y éticas. Es fundamental establecer marcos que aseguren la seguridad y la eficacia de nuevas tecnologías.
- Normativas internacionales: Desarrolladas para guiar el uso seguro de biotecnología en diferentes países.
- Debates éticos: La necesidad de considerar las implicaciones sociales y éticas de la ingeniería genética y la modificación de organismos.
Futuro de la biotecnología
Las tendencias actuales sugieren un futuro brillante para la biotecnología, con el potencial de revolucionar sectores clave. Las expectativas son altas y el potencial de innovación ilimitado, así como la capacidad de mejorar la calidad de vida a nivel global.
2. Innovaciones en biotecnología que transformarán el mercado
La biotecnología está en constante evolución, y su creciente influencia en diferentes sectores está cambiando la forma en que interactuamos con el entorno y la salud. A continuación, se detallan algunas de las principales innovaciones en biotecnología que se anticipa tendrán un impacto significativo en el mercado.
2.1 Terapias génicas personalizadas
Las terapias génicas están revolucionando el tratamiento de enfermedades genéticas. Estas técnicas permiten la modificación de los genes en las células de un paciente para corregir defectos que causan enfermedad. A futuro, se prevé que estas terapias se adapten individualmente a cada paciente, aumentando su eficacia.
2.2 Edición de genes CRISPR-Cas9
La tecnología de edición de genes CRISPR-Cas9 ha cambiado el juego en la investigación genética. Esta herramienta permite a los científicos realizar cambios precisos en el ADN, ofreciendo posibilidades para el tratamiento de enfermedades como el cáncer y la fibrosis quística.
2.3 Agricultura de precisión
La agricultura de precisión utiliza técnicas biotecnológicas para mejorar la producción agrícola y reducir el impacto ambiental. Mediante el uso de sensores y biotecnologías, los agricultores pueden optimizar el uso de recursos como agua y fertilizantes, aumentando la sostenibilidad de los cultivos.
2.4 Biofertilizantes y biopesticidas
- Biofertilizantes: Estos productos biológicos aumentan la fertilidad del suelo y promueven el crecimiento de las plantas, reduciendo la dependencia de fertilizantes químicos.
- Biopesticidas: Hechos a partir de organismos naturales, ayudan a controlar plagas con un menor impacto ambiental que los pesticidas sintéticos.
2.5 Medicina regenerativa
La medicina regenerativa se centra en reparar o reemplazar tejidos y órganos dañados. La biotecnología está facilitando avances en la creación de tejidos artificiales y en la utilización de células madre para tratamientos innovadores.
2.6 Producción de fármacos mediante microorganismos
Los microorganismos están siendo utilizados para producir fármacos de manera más eficiente y sostenible. La fermentación y la síntesis biológica permiten la producción de compuestos farmacéuticos a menor costo y con menor impacto ambiental.
2.7 Vacunas avanzadas basadas en ARN mensajero (ARNm)
Las vacunas basadas en ARNm han demostrado ser altamente efectivas, como se evidenció durante la pandemia de COVID-19. A medida que la investigación avanza, se espera que estas vacunas ayuden a combatir diversas enfermedades infecciosas y potencialmente incluso cánceres.
2.8 Bioinformática y análisis de datos genómicos
La bioinformática combina biología, informática y matemáticas para analizar grandes volúmenes de datos biológicos. Esta herramienta es fundamental para identificar patrones en datos genómicos que pueden ayudar a predecir enfermedades y personalizar tratamientos.
2.9 Biotecnología en el tratamiento del agua
La biotecnología medioambiental está emergiendo como una solución clave para el tratamiento de aguas residuales. Utilizando microorganismos, se puede tratar y purificar el agua de manera más eficaz, contribuyendo a la sostenibilidad y la conservación del agua.
2.10 Producción de biocombustibles
La investigación en biocombustibles ha crecido, impulsando alternativas sostenibles a los combustibles fósiles. Aprovechando materia orgánica y microorganismos, se busca reducir las emisiones de carbono y aumentar la seguridad energética.
2.11 Terapias celulares
Las terapias celulares, como el trasplante de células madre, están ganando terreno en el tratamiento de diversas condiciones de salud. Estas terapias permiten la regeneración de tejidos y ofrecen nuevas posibilidades en el tratamiento de enfermedades crónicas.
2.12 Producir alimentos sintéticos
La producción de alimentos sintéticos está ganando atención como una solución a la escasez alimentaria. A través de procesos biotecnológicos, se pueden cultivar carnes y productos lácteos sin necesidad de ganado, lo que reduce la huella ecológica.
2.13 Diagnósticos rápidos y precisos
Los diagnósticos moleculares permiten identificar enfermedades rápidamente, facilitando un tratamiento temprano. Las innovaciones en esta área están mejorando tanto la precisión como la velocidad de los diagnósticos.
2.14 Biotecnología y nanotecnología
La unión de la biotecnología y la nanotecnología está abriendo nuevas fronteras en el desarrollo de materiales innovadores. Estos materiais pueden tener aplicaciones en medicina, energía y productabilidad.
2.15 Innovaciones en pruebas de ADN
Las pruebas de ADN están convirtiéndose en una herramienta común para la personalización médica. Estas pruebas permiten conocer predisposiciones genéticas, facilitando tratamientos adecuados y prevención de enfermedades.
2.16 Biorremediación
La biorremediación utiliza organismos vivos para eliminar contaminantes del medio ambiente. Esta técnica natural es fundamental para restaurar ecosistemas dañados e impulsar la sostenibilidad.
2.17 Nuevas fuentes de proteínas
La investigación en nuevas fuentes de proteínas, como insectos y algas, está desafiando nuestras concepciones sobre la alimentación. Estas opciones son más sostenibles y ricas en nutrientes, aportando soluciones a la demanda alimentaria creciente.
2.18 Detección de enfermedades emergentes
Las innovaciones en biotecnología están mejorando la detección temprana de enfermedades emergentes, ayudando a contener brotes y mejorar la salud pública.
2.19 Impresión 3D de tejidos y órganos
La impresión 3D en biotecnología promete revolucionar la medicina al permitir la creación de tejidos y órganos artificiales para trasplantes y pruebas de medicamentos.
2.20 Fármacos biológicos
Los fármacos biológicos, derivados de organismos vivos, están cambiando la manera en que se tratan muchas enfermedades crónicas, proporcionando alternativas más efectivas y con menos efectos secundarios.
3. Las mejores oportunidades de inversión en biotecnología para emprendedores
La biotecnología está en la cúspide de la innovación, ofreciendo a los emprendedores diversas oportunidades de inversión que pueden generar altos retornos. A continuación, exploraremos algunas de las áreas más prometedoras en este sector.
3.1. Terapias génicas
Las terapias génicas son uno de los segmentos más emocionantes en biotecnología. Estas técnicas utilizan material genético para tratar o prevenir enfermedades. Invertir en empresas que desarrollan estas tecnologías puede resultar muy lucrativo, ya que muchas enfermedades genéticas carecen de tratamientos efectivos.
3.2. Edición genética
La edición genética, especialmente a través de la tecnología CRISPR, está revolucionando la biotecnología. Los emprendedores pueden invertir en startups que están aplicando esta técnica en medicina, agricultura y bioproductos, lo que abre un abanico de oportunidades en múltiples sectores.
3.3. Biomedicina personalizada
La biomedicina personalizada se centra en tratamientos específicamente diseñados para individuos según su perfil genético. El crecimiento de este sector ha sido exponencial y promete seguir creciendo. Los inversores pueden buscar empresas que desarrollen soluciones a medida para el tratamiento de diversas condiciones médicas.
3.4. Agricultura biotecnológica
La biotecnología también se aplica en la agricultura. Invertir en empresas que desarrollan cultivos genéticamente modificados para resistir plagas o mejorar la producción puede ser una opción rentable. Además, el uso de tecnologías sostenibles en esta área está en aumento, lo que la convierte en un campo atractivo para los emprendedores.
3.5. Desarrollo de vacunas
El desarrollo de vacunas es un aspecto crítico de la biotecnología. La pandemia de COVID-19 ha demostrado la rapidez con la que se pueden desarrollar e implementar vacunas, creando un espacio de inversión activo en empresas dedicadas a esta área. Los emprendedores deben prestar atención a las empresas que desarrollemos tecnologías de vacunación innovadoras.
3.6. Diagnóstico molecular
Las técnicas de diagnóstico molecular están revolucionando la forma en que se detectan y tratan las enfermedades. Las inversiones en empresas que ofrecen estas pruebas diagnósticas son cada vez más comunes. Los emprendedores pueden beneficiarse de este creciente mercado al explorar tecnologías avanzadas que mejoren la precisión y rapidez de los diagnósticos.
3.7. Biofármacos
Los biofármacos son medicamentos derivados de organismos vivos. Este campo está en constante evolución, ofreciendo oportunidades de inversión en compañías que desarrollan tratamientos innovadores para enfermedades crónicas y raras. La demanda de biofármacos sigue creciendo y presenta grandes perspectivas para emprendedores.
3.8. Biotecnología ambiental
La biotecnología ambiental busca soluciones sostenibles para retos ecológicos. Invertir en empresas que utilizan microorganismos para limpiar suelos contaminados o tratar aguas residuales puede ser no solo rentable, sino también socialmente responsable. La presión por prácticas sostenibles hace que este campo sea atractivo para nuevos inversores.
3.9. Productos alimentarios biotecnológicos
La producción de alimentos a través de biotecnología está en auge. Inversiones en empresas que crean alimentos alternativos, como carne cultivada en laboratorio o productos lácteos sin animales, están ganando terreno. Este cambio en los hábitos alimenticios es una tendencia que los emprendedores no deben pasar por alto.
3.10. Servicios de bioinformática
La bioinformática juega un papel esencial en la biotecnología moderna. Las empresas que ofrecen soluciones de bioinformática para el análisis de datos biológicos son fundamentales. Los emprendedores pueden considerar la inversión en startups que desarrollen software para la gestión y análisis de datos genéticos y clínicos.
3.11. Innovaciones en fabricación biotecnológica
La fabricación biotecnológica se refiere a procesos industriales que utilizan organismos vivos. Desde la producción de enzimas hasta la síntesis de compuestos químicos, hay una claro espacio para la inversión en tecnologías que optimizan estos procesos. Las empresas que se centran en la eficiencia y sostenibilidad son prometedoras.
3.12. Proyectos de investigación y desarrollo (I+D)
El I+D es crucial en biotecnología. Los emprendedores pueden buscar financiar proyectos de investigación que estén en fases innovadoras o de aplicación. Asociarse con universidades y centros de investigación puede abrir puertas a oportunidades significativas en esta área.
3.13. Startups de biotecnología emergentes
El panorama de startups en biotecnología es amplio y variado. Identificar y seguir a empresas emergentes con ideas innovadoras o que atiendan nichos específicos puede ser una estrategia efectiva. La inversión en estas startups puede conducir a altos rendimientos en el futuro.
3.14. Infraestructura y tecnología de soporte biotecnológico
Las tecnologías de soporte para el desarrollo de biotecnología, como el diseño de instalaciones o el equipamiento especializado, son esenciales. Invertir en empresas que ofrecen estas soluciones puede ser una forma indirecta de participar en el rápido crecimiento de la industria.
3.15. Análisis de tendencias de mercado
Los emprendedores deben estar al tanto de las tendencias de mercado en biotecnología. Un análisis detallado de estas tendencias puede ayudar a dirigir las inversiones hacia áreas con alto potencial de crecimiento.
3.16. Consultoría en biotecnología
La consultoría en biotecnología es otro campo atractivo para emprendedores. Ofrecer servicios de asesoramiento a empresas establecidas que buscan innovar puede resultar rentable, especialmente en campos técnicos y de regulación.
3.17. Participación en incubadoras y aceleradoras
Las incubadoras y aceleradoras de biotecnología son excelentes plataformas para emprendedores. Participar en estos programas no solo proporciona capital, sino también mentoría y contactos en la industria que pueden resultar decisivos para el éxito.
3.18. Asociaciones estratégicas
Formar asociaciones estratégicas con otras empresas de biotecnología o sectores relacionados puede ampliar las oportunidades de inversión. Colaboraciones en investigación, desarrollo de productos o comercialización permiten a los emprendedores aumentar su impacto en el mercado.
3.19. Educación y capacitación en biotecnología
La demanda de educación y capacitación especializada en biotecnología está en aumento. Invertir en programas educativos, tanto presenciales como online, puede representar una oportunidad significativa a medida que las empresas buscan talento capacitado.
3.20. Proyectos de sostenibilidad
Finalmente, los proyectos de sostenibilidad dentro de la biotecnología están ganando notoriedad. Empresas que desarrollan soluciones para reducir el impacto ambiental mediante biotecnología son cada vez más relevantes y demandadas, lo que representa una oportunidad de inversión atractiva para los emprendedores.
4. Casos de éxito: Emprendedores que han aprovechado las tendencias biotecnológicas
El ámbito de la biotecnología ha visto un auge significativo en la última década, creando un terreno fértil para los emprendedores que buscan innovar y hacer la diferencia en el sector salud, agrícola y ambiental. A continuación, presentaremos varios casos de éxito que ilustran cómo estos emprendedores han utilizado tendencias biotecnológicas para transformar sus ideas en negocios prósperos.
1. Biotech Startups que marcan la diferencia
Las startups biotecnológicas han surgido como un modelo de negocio clave. Aquí hay algunos ejemplos notables:
- Genomatix: Esta empresa se ha especializado en el análisis de datos genómicos, ofreciendo soluciones para la investigación y desarrollo de nuevos tratamientos.
- Amgen: Fundada por un grupo de científicos, se ha convertido en una de las empresas biofarmacéuticas más grandes del mundo, centrada en la investigación de medicamentos para enfermedades graves.
- Ginkgo Bioworks: Con un enfoque en la ingeniería genética, Ginkgo Bioworks ha analizado microorganismos para crear productos que abarcan desde perfumes hasta alimentos.
2. Innovaciones en el ámbito agrícola
La biotecnología agrícola ha permitido a emprendedores desarrollar soluciones que enfrentan los retos de la producción de alimentos:
- Impossible Foods: Utiliza tecnología biotecnológica para crear productos similares a la carne que son más sostenibles y menos dañinos para el medio ambiente.
- Pivot Bio: Se centra en la producción de fertilizantes naturales a través de microorganismos, reduciendo así la dependencia de químicos en la agricultura.
3. Avances en la salud humana
La biotecnología también ha potenciado un cambio radical en el sector salud:
- 23andMe: Esta compañía ha facilitado la realización de análisis genéticos al gran público, permitiendo a los usuarios conocer su predisposición genética a diversas condiciones de salud.
- CRISPR Therapeutics: Pionera en el uso de tecnología CRISPR, esta empresa se dedica a la edición genética para tratar enfermedades genéticas.
4. Biotecnología ambiental
La necesidad de proteger el medio ambiente ha llevado a tecnologías innovadoras:
- Bio-bean: Convierte desechos de café en biocombustibles, ayudando a reducir el desperdicio y a crear energía sostenible.
- Novozymes: Esta empresa se especializa en enzimas y microorganismos que ayudan a hacer procesos industriales más sostenibles y eficientes.
5. Emprendedores en biotecnología de consumo
Algunos emprendedores han aprovechado las tendencias biotecnológicas para crear productos innovadores para el consumidor:
- Perfect Day: Produce productos lácteos a partir de fermentación, ofreciendo alternativas sostenibles y libres de crueldad animal.
- Ecovative Design: Utiliza micelio para crear materiales sostenibles que pueden reemplazar al plástico y otros materiales dañinos para el medio ambiente.
6. Tendencias futuras en biotecnología
El interés en la biotecnología sigue creciendo, y a medida que estos emprendedores continúan innovando, las tendencias futuras el sector incluyen:
- Medicina personalizada: Tecnologías que adaptan tratamientos a cada individuo basándose en su perfil genético.
- Construcción de bioproductos: Creación de materiales y productos que usan procesos biológicos, aumentando su sostenibilidad.
Estos casos de éxito son solo algunos ejemplos de cómo los emprendedores están aprovechando las oportunidades que ofrece la biotecnología. La pasión por la innovación y un enfoque en la sostenibilidad y la mejora de la calidad de vida están guiando estas iniciativas hacia el éxito.
5. Cómo prepararse para las futuras tendencias en biotecnología
La biotecnología está en constante evolución. Para adaptarse y prepararse para las futuras tendencias, es crucial que los profesionales y las organizaciones sigan ciertos pasos estratégicos. A continuación, se presentan algunas recomendaciones clave.
1. Educación continua y formación
- Es importante actualizar conocimientos regularmente sobre los avances en biotecnología.
- Participar en cursos online, seminarios y talleres sobre nuevas técnicas y tecnologías.
- Leer publicaciones científicas y asistir a conferencias para entender y anticipar nuevas tendencias.
2. Inversión en tecnología
Las herramientas tecnológicas son fundamentales para mantenerse competitivo en el sector de la biotecnología. Considera lo siguiente:
- Adquirir equipos de última generación que faciliten la investigación y el desarrollo (I+D).
- Implementar software especializado para el análisis de datos biotecnológicos.
- Aprovechar la inteligencia artificial y la automatización para mejorar la eficiencia en los procesos.
3. Colaboración interdisciplinaria
La biotecnología se beneficia enormemente de la colaboración entre diversas disciplinas. Aquí hay algunos enfoques:
- Formar equipos multidisciplinarios que incluyan biólogos, químicos, informáticos y expertos en ética.
- Fomentar la colaboración con universidades y centros de investigación para acceder a nuevos conocimientos y tecnologías.
- Desarrollar alianzas con empresas del sector para co-crear soluciones innovadoras.
4. Adaptación a regulaciones y éticas
El marco regulatorio en biotecnología es amplio y está en constante cambio. Para estar preparado:
- Conocer y entender las regulaciones locales e internacionales que afectan la biotecnología.
- Estar al tanto de las normativas éticas y las mejores prácticas en investigación y desarrollo.
- Incorporar prácticas de responsabilidad social en todos los proyectos biotecnológicos para garantizar la aceptación pública.
5. Innovación constante
La innovación es la clave de éxito en la biotecnología. Aquí hay algunos consejos para fomentar un ambiente innovador:
- Crear un laboratorio de ideas donde el personal pueda proponer y desarrollar nuevos proyectos.
- Incentivar el pensamiento creativo mediante concursos y hackathons de biotecnología.
- Estar abierto a nuevas soluciones que puedan no estar en la práctica estándar del sector.
6. Análisis de tendencias del mercado
Para anticiparse a futuras tendencias, es vital realizar un seguimiento continuo del mercado:
- Utilizar herramientas analíticas para estudiar el comportamiento del consumidor y sus preferencias en biotecnología.
- Identificar cambios en la percepción pública de la biotecnología que puedan impactar en el desarrollo de productos.
- Monitorear la inversión en biotecnología para identificar áreas de interés emergentes.
7. Sostenibilidad y medio ambiente
Las preocupaciones ambientales están llevando a la biotecnología hacia un enfoque más sostenible. Para prepararse:
- Implementar procesos más sostenibles en producción y desarrollo.
- Investigar alternativas bio-basadas que disminuyan el impacto ambiental.
- Desarrollar políticas de sostenibilidad en la investigación biotecnológica.
8. Involucramiento en la comunidad
El involucramiento comunitario puede ser una gran manera de anticiparse a tendencias:
- Participar en foros y grupos de discusión sobre biotecnología y temas relacionados.
- Colaborar con organizaciones no lucrativas para aumentar la conciencia sobre la biotecnología.
- Utilizar plataformas sociales para compartir conocimientos y recursos sobre biotecnología.
9. Desarrollo de habilidades blandas
No se trata solo de habilidades técnicas. Las habilidades blandas son igualmente importantes:
- Fomentar el trabajo en equipo y la comunicación efectiva entre los miembros del equipo.
- Desarrollar habilidades de liderazgo para gestionar proyectos complejos en biotecnología.
- Practicar la adaptabilidad y la resiliencia para afrontar los cambios en un sector en rápida evolución.
10. Investigación y desarrollo proactivo
Finalmente, mantener un enfoque proactivo en I+D es fundamental:
- Establecer un calendario de investigación que revise regularmente las metas y objetivos.
- Buscar financiamiento para proyectos innovadores antes de que surjan tendencias.
- Evalúa continuamente los resultados de la investigación para mejorar procesos y métodos.